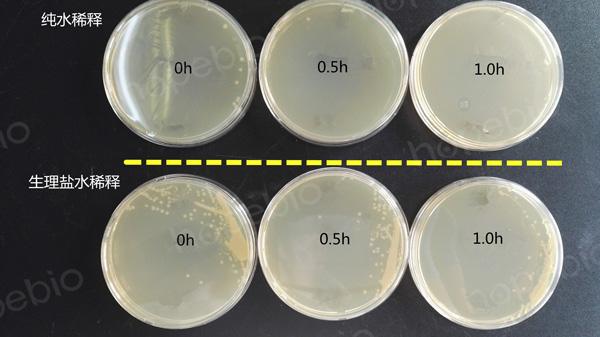

一、弧菌简介
弧菌是一种可以在温带水环境下发现的细菌属。他们通常具有共同的特征和习性。如:
(1)革兰氏阴性,短小弯曲弧状,无芽孢,多数有鞭毛、菌毛(如图1);
(2)具有一端单生鞭毛,运动迅速;
(3)多数菌株生长需要2%-3%氯化钠;
(4)最适生长温度为30℃-37℃;
(5)对热敏感,90℃ 1min即可杀死,50℃ 20min或65℃ 5min也可达到杀菌效果;
(6)耐碱怕酸,1%醋酸或50%食醋中1min死亡。
图1 弧菌的显微形态
二、样品处理规定
对于可能含有弧菌的样品的保存和检验,各相关标准均作了规定:
(1)非冷冻样品采集后应立即置7℃~10℃冰箱保存,尽可能及早检验(GB4789.7-2013 食品微生物学检验 副溶血性弧菌检验);
(2)新鲜样品采集后应于3h内完成检验,若不能在规定时间内完成,则应将样品置于7℃~10℃条件下保存,并尽可能在24h内完成检验(GB4789.44-2020 食品微生物学检验 创伤弧菌检验);
(3)样品采集后应立即在7℃~10℃保存,24h内检验。如果样品需要冷冻,于-18℃保存,24h内检验。为了最大限度地保证弧菌的存活率,应避免样品与冰直接接触(SN/T 1022-2001 进出口食品中霍乱弧菌检验方法)。
通常来说,样品保存需放在4℃条件下,但弧菌检验标准中,对样品的保存条件,均要求7℃~10℃,特意避开了4℃,这是因为创伤弧菌在4℃条件下极易形成活而不可培养的状态(参考GB4789.44-2020 食品微生物学检验 创伤弧菌检验)。
三、保存温度
基于弧菌对温度的敏感性,实验室在保存弧菌的标准菌株的时候,也要注意温度条件。对于储备菌株,有条件的可以保存在-70℃超低温冰箱中,一般室温指25℃左右,因为白天晚上会有温差,除非有温控设备,否则没办法保证一般环境温度在25℃-28℃之间,其实只要温度不是太高,放在室内环境中短期内是没有问题的。
对于真空冷冻干燥的菌株,未开封状态下于-20℃冰箱中至少可以保存2年。
对于工作菌株,本实验室在长期工作实践中发现,由于冬天室温偏低(不高于10℃),也不利于弧菌的保存。一周内所划平板,尽管也有尚存活的弧菌,但其活力已远不能满足试验可靠性需要,因此为能保证每次试验的可靠性,建议每次接菌都用前一天在3%NaCl TSA平板上划线培养所得的新鲜菌落;为保证试验的连续性,在试验阶段应该每天划平板培养;培养好的平板,用完后直接放回培养箱,当天下午下班前拿出灭菌丢弃。
务必记住,弧菌液体试管和划线后的平板,一定不能放置在4℃冰箱中。
四、纯化培养与菌悬液制备
因为多数弧菌具有嗜盐性,而在无盐的环境中生长不好甚至不生长,因此在培养该菌时,通常需要加入2%-3%的NaCl,而在初步筛选出该菌后进行纯化时,各标准都要求用含3%NaCl的营养琼脂进行纯化,也是基于这个原因。
为方便副溶血性弧菌的鉴定,我公司开发出了副溶血性弧菌鉴定条和嗜盐试验系列生化管(编号分别为HBIS02、GS014、GS015、SN052、GS016),在使用这些产品时,需要挑取纯化的菌落做成菌悬液,再往管中滴加,此时需要注意,务必使用0.85%生理盐水进行菌悬液的制备,而不能用无菌纯净水,并且制成菌悬液后要尽快滴加完毕,否则会影响结果的判定。
试验证明,用生理盐水制备的菌液,放置1h后菌数降低至初始状态的50%左右;而用纯水制备的菌液,放置1小时几乎无活菌。即使稀释后立即涂布,纯水悬液中的菌数也会迅速降至生理盐水稀释液中菌数的10%以下(如图2)。
图2 副溶血性弧菌ATCC 17802用纯水和生理盐水稀释后放置不同时间后的菌数
综上所述,为保证菌种的存活,弧菌菌种应在-70℃超低温保存或室温,一定不能放在4℃环境保存;为保证试验结果的准确性,弧菌鉴定试验中,应该尽量用新鲜的菌板,挑单菌落至无菌生理盐水制成菌液,制成的菌液不宜搁置时间太长,必要时需要重新制备。
相关产品:
HBI副溶血性弧菌生化鉴定条(SN)-点击查看产品详情
10%NaCl胰胨水-点击查看产品详情
8%NaCl胰胨水-点击查看产品详情
6%NaCl胰胨水-点击查看产品详情
3%NaCl胰胨水-点击查看产品详情
相关标准:
GB 4789.7-2013 副溶血性弧菌检验 点击下载
GB 4789.44-2020 食品微生物学检验 创伤弧菌检验 点击下载
SNT1022-2010 进出口食品中霍乱弧菌的检测方法 点击下载
注:本文属海博生物原创,未经允许不得转载。
上一篇:专性厌氧菌的培养方法及注意事项
下一篇:酵母菌的糖发酵试验-杜氏管发酵法


 海博微信公众号
海博微信公众号
 海博天猫旗舰店
海博天猫旗舰店


 海博微信公众号
海博微信公众号
 海博天猫旗舰店
海博天猫旗舰店